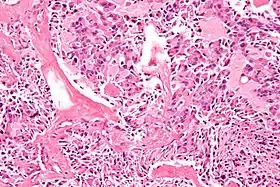

تكون الأورام الصماوية المتعددة
تكون الأورام الصماوية المتعددة (بالإنجليزية: Multiple endocrine neoplasia) اختصارها MEN تشمل عدة متلازمات متميزة تضم أورام من الغدد الصماء، كلٌ له طابعه الخاص. في بعض الحالات تكون الأورام خبيثة وفي البعض الآخر تكون حميدة. توجد بعض المتلازمات التي تحتوي على أورام حميدة أوخبيثة ناشئة من أنسجة غير صماء.
| تكون الأورام الصماوية المتعددة | |
|---|---|
![]() صورة مجهرية لسرطان الغدة الدرقية اللبيّ والذي قد يظهر في MEN 2A و MEN 2B. صبغة الهيماتوكسيلين واليوزين صورة مجهرية لسرطان الغدة الدرقية اللبيّ والذي قد يظهر في MEN 2A و MEN 2B. صبغة الهيماتوكسيلين واليوزين | |
| معلومات عامة | |
| الاختصاص | علم الغدد الصم |
| من أنواع | أورام الغدد الصماء |
يتم توريث متلازمات MEN في صورة وراثة صبغية جسدية سائدة.[1]
التسمية
تم استبدال الأسماء القديمة،" تكون الأورام الغدية الحميدة الصماوية المتعددة (MEA) بالتسمية الحالية (MEN).
مصطلح "تكون الأورام الصماوية المتعددة" يطلق حينما يوجد ورمين صماويين أو أكثر في شخص واحد ووجود دليل على حدوث طفرة مُسبِبَة أو انتقال وراثي.
تم تقديم المصطلح في عام 1968 ولكن وصف الحالة يرجع لعام 1903.[2]
الحالات المرتبطة
متلازمة كارني و داء فون هيبل - لينداو ولكنهما ليسا مصنفان بصورة رسمة تحت مصطلح الأورام الصماوية المتعددة.
التاريخ
في 1903 وصف أردهايم حالة شخص مصاب بضخامة الأطراف مصاب بورم نخامي غدي حميد وثلاث غدد جار درقية متضخمة.
في 1953 وثق Underdahl et al. سلسلة حالات من 8 أشخاص بمتلازمة من أورام غدية حميدة في الغدة النخامية، الجار درقية وجزر البنكرياس.
في 1954 دوَّن Wermer بأن انتقال المتلازمة يحدث في صورة سائدة.
في 1959 وصف Hazard et al. سرطان الغدة الدرقية اللبيّ الصلب.
في 1961 وصف Sipple مزيج من ورم القواتم، سرطان الغدة الدرقية اللبي وورم غدي جار درقي.
في 1966 وصف Williams et al. مزيج من الأورام العصبية المخاطية، ورم القواتم وسرطان الغدة الدرقية اللبيّ.
في 1968 قدّم Steiner et al. مصطلح تكون الأورام الصماوية المتعددة كوصف لاضطرابات تشمل مزيج من أورام غدد صماء
في 1988 تم تحديد موضع جين MEN1 على الكروموسوم 11.
في 1998 تم استنساخ جين MEN1.
المقارنة

النسب المذكورة في الجدول أدناه تشير إلى كيفية أن جزء كبير من الناس ينمو لديهم نوع معين من الأورام.
| السمة | MEN 1 | MEN 2 | ||
|---|---|---|---|---|
| تكون الورم الصماوي المتعدد النوع 2 | تكون الورم الصماوي المتعدد النوع 2 ب | FMTC | ||
| مسماه | متلازمة ورمر | متلازمة سيبل | (متعدد) | (لايوجد) |
| الوراثة المندلية البشرية عبر الإنترنت | قالب:OMIM4 | قالب:OMIM4 | قالب:OMIM4 | قالب:OMIM4 |
| أورام البنكرياس | الورم الغاستريني (50%[3]), الورم الجزيري (20%[3]), الورم المفرز لعديدات الببتيد المعوية المنشأ الفعالة وعائياً, الورم الغلوكاغوني, PPoma |
- | - | - |
| ورم الغدة النخامية | 66%[3] | - | - | - |
| الورم الليفي الوعائي | 64%*[4] | - | - | - |
| الورم الشحمي | 17%*[4] | - | - | - |
| فرط تنسج الغدة جارة الدرقية | 90%[3] | 50%[3] | - | - |
| سرطان الغدة الددرقية اللبيّ | - | 100%[3] | 85%[3] | 100% |
| ورم القواتم | - | >33%[3] | 50% | - |
| الخلقة الجسدية مرفانية الشكل | - | - | 80% | - |
| الورم العصبي المخاطي | - | - | 100%[3] | - |
| الجينات | MEN1 (قالب:OMIM4) | RET (قالب:OMIM4) | RET (قالب:OMIM4) | RET (قالب:OMIM4), NTRK1 (قالب:OMIM4) |
| معدل الانتشار التقريبي | 1 in 35,000 (1 in 20,000 to 1 in 40,000)[5] |
1 in 40,000[6] | 1 in 1,000,000 (1 in 600,000[7] to 1 in 4,000,000[8])[9] | |
| الوصف المبدأي (سنة) | 1954[10] | 1961[11] | 1965 | |
*- تشير إلى المرضى المصابين بMEN1 و الورم الغاستريني معاً.
المراجع
- "multiple endocrine neoplasia" في معجم دورلاند الطبي
- Carney JA (Feb 2005). "Familial multiple endocrine neoplasia: the first 100 years". Am. J. Surg. Pathol. 29 (2): 254–74. doi:10.1097/01.pas.0000147402.95391.41. PMID 15644784. مؤرشف من الأصل في 16 يونيو 2013. الوسيط
|CitationClass=تم تجاهله (مساعدة) - Table 4-7 in:Elizabeth D Agabegi; Agabegi, Steven S. (2008). Step-Up to Medicine (Step-Up Series). Hagerstwon, MD: Lippincott Williams & Wilkins. ISBN 0-7817-7153-6. الوسيط
|CitationClass=تم تجاهله (مساعدة) - Asgharian, B; Turner, ML; Gibril, F; Entsuah, LK; Serrano, J; Jensen, RT (November 2004). "Cutaneous tumors in patients with multiple endocrine neoplasm type 1 (MEN1) and gastrinomas: prospective study of frequency and development of criteria with high sensitivity and specificity for MEN1". The Journal of Clinical Endocrinology and Metabolism. 89 (11): 5328–36. doi:10.1210/jc.2004-0218. PMID 15531478. الوسيط
|CitationClass=تم تجاهله (مساعدة) - 123I labeled metaiodobenzylguanidine for diagnosis of neuroendocrine tumors. Jiang L, Schipper ML, Li P, Cheng Z, Reports in Medical Imaging. 2009: 2 79-89 "نسخة مؤرشفة". Archived from the original on 14 مارس 2017. اطلع عليه بتاريخ 13 فبراير 2018. الوسيط
|CitationClass=تم تجاهله (مساعدة)صيانة CS1: BOT: original-url status unknown (link) - Dora JM, Siqueira DR, Meyer EL, Puñales MK, Maia AL (November 2008). "Pancreatitis as the first manifestation of multiple endocrine neoplasia type 2A". Arq Bras Endocrinol Metabol. 52 (8): 1332–6. doi:10.1590/S0004-27302008000800021. PMID 19169490. الوسيط
|CitationClass=تم تجاهله (مساعدة) - Marx, Stephen J (2011). "Chapter 41: Multiple endocrine neoplasia". In Melmed, Shlomo (المحرر). Williams Textbook of Endocrinology, 12th ed. صفحات 1728–1767. الوسيط
|CitationClass=تم تجاهله (مساعدة) - Moline J, Eng C (2011). "Multiple endocrine neoplasia type 2: An overview". Genetics in Medicine. 13 (9): 755–764. doi:10.1097/GIM.0b013e318216cc6d. PMID 21552134. مؤرشف من الأصل في 13 يناير 2017. الوسيط
|CitationClass=تم تجاهله (مساعدة) - Martino Ruggieri (2005). Neurocutaneous Disorders : The Phakomatoses. Berlin: Springer. ISBN 3-211-21396-1. الوسيط
|CitationClass=تم تجاهله (مساعدة) - Chapter: Multiple Endocrine Neoplasia Type 2B by Electron Kebebew, Jessica E. Gosnell and Emily Reiff. Pages 695-701. [وصلة مكسورة] This reference quotes a prevalence of 1 in 40,000, but this figure is inconsistent with the same reference's calculated incidence of 4 per 100 million per year for MEN2B. - Wermer P (1954). "Genetic aspects of adenomatosis of endocrine glands". Am. J. Med. 16 (3): 363–71. doi:10.1016/0002-9343(54)90353-8. PMID 13138607. مؤرشف من الأصل في 15 ديسمبر 2019. الوسيط
|CitationClass=تم تجاهله (مساعدة) - Sipple JH (1961). "The association of pheochromocytoma with carcinoma of the thyroid gland". Am. J. Med. 31: 163–6. doi:10.1016/0002-9343(61)90234-0. الوسيط
|CitationClass=تم تجاهله (مساعدة)
- بوابة طب